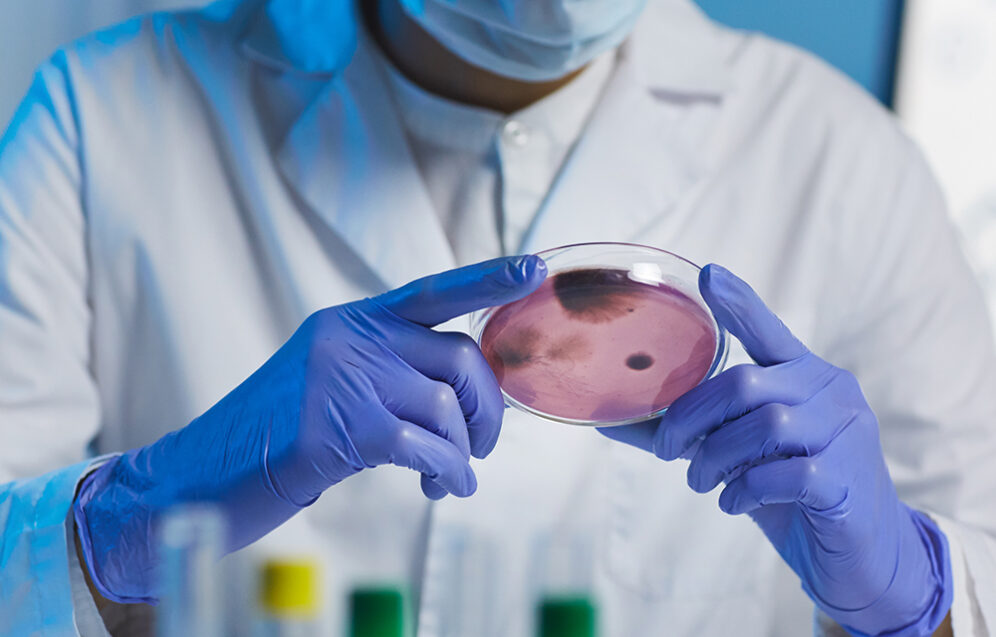
Komórki macierzyste w chirurgii plastycznej – przyszłość regeneracji skóry

The safety and efficacy of cosmetic surgery – a review of clinical trials

Bezpieczeństwo i skuteczność operacji plastycznych – przegląd badań klinicznych
Operacje plastyczne to jedne z najpopularniejszych procedur chirurgicznych na świecie. Pacjenci poszukują poprawy wyglądu i samopoczucia, ale każda operacja niesie pewne ryzyko. Świadomość zagrożeń i sposobów ich minimalizacji pomaga podejmować przemyślane decyzje. Artykuł opiera się na wynikach badań klinicznych oraz zaleceniach uznanych organizacji medycznych.
Dlaczego bezpieczeństwo operacji plastycznych jest kluczowe?
Bezpieczeństwo stanowi fundament każdej operacji plastycznej. Najczęstsze powikłania to:
- Infekcje – szczególnie po inwazyjnych zabiegach, takich jak lifting twarzy czy liposukcja.
- Krwawienia pooperacyjne – częściej obserwowane po liposukcji dużych obszarów.
- Reakcje alergiczne i problemy z gojeniem ran.
Badania wskazują, że wiek, cukrzyca i palenie tytoniu znacząco zwiększają ryzyko komplikacji pooperacyjnych.
Skuteczność popularnych zabiegów plastycznych
Lifting twarzy
Lifting twarzy zapewnia efekty estetyczne utrzymujące się 7–10 lat. W badaniach 90% pacjentów było zadowolonych rok po zabiegu, a 70% po pięciu latach. Najważniejszy czynnik: doświadczenie chirurga.
Liposukcja
Liposukcja daje trwałe efekty tylko przy zachowaniu zdrowego stylu życia. Pacjenci wracający do złych nawyków żywieniowych obserwują powrót tkanki tłuszczowej w innych obszarach ciała.
Powiększanie piersi
98% pacjentek deklaruje zadowolenie z rezultatów powiększania piersi. Należy jednak pamiętać, że implanty mogą wymagać wymiany po 10–15 latach.
Czynniki wpływające na bezpieczeństwo operacji
Do kluczowych czynników należą:
- Choroby przewlekłe – np. cukrzyca zwiększa ryzyko infekcji i problemów z gojeniem ran.
- Wiek – osoby powyżej 50 roku życia częściej doświadczają komplikacji.
Technologie poprawiające bezpieczeństwo
Nowoczesne technologie zmniejszają ryzyko powikłań i skracają rekonwalescencję:
- Lasery i ultradźwięki – szybsze gojenie ran, mniejsze ryzyko infekcji.
- Mikrochirurgia – precyzyjne łączenie naczyń krwionośnych, lepsze wyniki przeszczepów.
Znaczenie kwalifikacji chirurga i przygotowania pacjenta
- Doświadczenie chirurga: certyfikaty i praktyka znacząco zmniejszają ryzyko komplikacji.
- Przygotowanie pacjenta: konsultacja, dieta, nawodnienie, zaprzestanie palenia.
Wnioski i rekomendacje
- Wybierz doświadczonego chirurga z odpowiednimi kwalifikacjami.
- Stosuj się do zaleceń przed i po zabiegu.
- Bądź świadomy możliwych powikłań i planuj okres rekonwalescencji.
Operacje plastyczne mogą znacząco poprawić wygląd i jakość życia, pod warunkiem zachowania ostrożności, świadomego przygotowania i wyboru specjalisty.